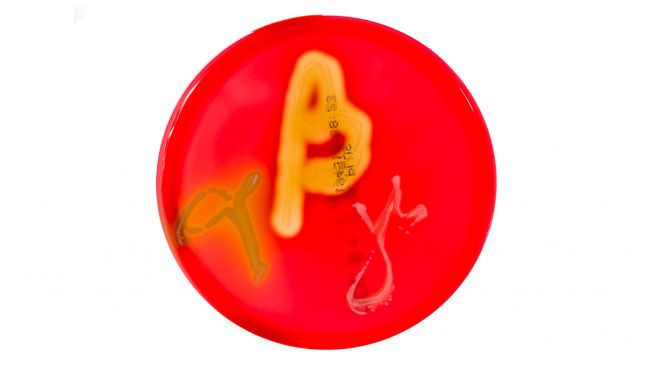
Figura&nbsp;1. Cultivos en placas de Petri en agar sangre que muestran hem&oacute;lisis alfa, beta y gamma. Fuente:&nbsp;Mibilehr https://creativecommons.org/licenses/by-sa/4.0/deed.ene&nbsp;

Diagnóstico laboratorial: Fiebre aftosa
¿Qué métodos de diagnóstico laboratorial puedo usar para diagnosticar fiebre aftosa? ¿Cuál debo elegir según la situación? ¿Cómo interpreto los resultados?
Noticias, eventos y reportajes de actualidad del sector porcino
Los eventos de porcicultura que se organizan en México y todo el mundo
Un resumen semanal de las novedades de 3tres3 México
Boletín de noticias sobre el mundo del porcino
La salud del cerdo: noticias y artículos sobre PRRS, PCV2, bioseguridad, etc., guía de enfermedades del cerdo, atlas de patología, casos clínicos...
Cómo realizar una necropsia en un cerdo, paso a paso, de una forma muy visual y práctica.
Biocheck.UGent es un sistema de puntuación científico independiente, basado en riesgos, para evaluar la calidad de su bioseguridad en la granja.
Toda la información relevante sobre PPA: cómo reconocer la enfermedad, cómo se transmite, imágenes de lesiones, últimas noticias, guías...
Descripción de las enfermedades y afecciones más importantes del cerdo
Lesiones y signos de las principales enfermedades del cerdo
Herramienta para diagnosticar enfermedades del cerdo
Un diccionario sobre terminología específica de la porcicultura
Calcula la cantidad de medicamento a incorporar en el agua cuando usamos un dosificador de flujo
Un resumen semanal de las novedades de 3tres3 México
Precios del cerdo por países. Producción y comercio de carne de cerdo. Noticias del mercado del cerdo y las materias primas
Últimas cotizaciones del mercado porcino mexicano y de los principales países. Históricos de precios en diversas monedas y en formato gráfico.
Últimas cotizaciones de las materias primas para alimento de cerdos. Gráficas históricas junto con el precio del cerdo y estimación del precio del alimento.
Calcula tu costo de producción, compáralo con la referencia y valora como afecta cada parámetro al costo de producción total.
Datos de censos, producción de carne, número de granjas, etc.
Datos de producción y comercio mundial de las principales materias primas para la alimentación de cerdos como maíz y soya
Un resumen semanal de las novedades de 3tres3 México
Artículos sobre nutrición y alimentación de cerdos, características de las materias primas y aditivos para porcino y precios de las materias primas
Últimas cotizaciones de las materias primas para alimento de cerdos. Gráficas históricas junto con el precio del cerdo y estimación del precio del alimento.
Datos de producción y comercio mundial de las principales materias primas para la alimentación de cerdos como maíz y soya
Fichas técnicas de materias primas y aditivos para cerdos. Información de valores nutricionales, producción y comercio, estudios recientes...
Un diccionario sobre terminología específica de la porcicultura
Utiliza esta herramienta para diagnosticar problemas con el índice de conversión. Haz clic en el diagrama de flujo o en los botones dentro del texto para navegar por las distintas partes de la herramienta.
Un resumen semanal de las novedades de 3tres3 México
Artículos sobre selección genética y reproducción del cerdo.
Compara los datos productivos, calcula el número de plazas para cerdas, transición y cebo y visualiza tus tareas sobre el calendario según cada tipo de MEB.
Calcula las entradas de cerdas necesarias en una granja activa, una granja que inicia la actividad o una granja en expansión
Herramienta para comparar los datos reproductivos de tu granja con la base de datos BDporc y ver la evolución de los parámetros reproductivos de BDporc
Un diccionario sobre terminología específica de la porcicultura
Utiliza esta herramienta para investigar porque tu tasa de partos es inferior a la ideal. Da clic en el diagrama de flujo o en los botones dentro del texto para navegar por las distintas partes de la herramienta.
Un resumen semanal de las novedades de 3tres3 México
Manejo y gestión de las granjas de cerdos y organización del trabajo en las fases de producción: gestación, lactancia, engorda, sistema en bandas...
Compara los datos productivos, calcula el número de plazas para cerdas, transición y cebo y visualiza tus tareas sobre el calendario según cada tipo de MEB.
Calcula las entradas de cerdas necesarias en una granja activa, una granja que inicia la actividad o una granja en expansión
Calcula tu costo de producción, compáralo con la referencia y valora como afecta cada parámetro al costo de producción total.
Herramienta para comparar los datos reproductivos de tu granja con la base de datos BDporc y ver la evolución de los parámetros reproductivos de BDporc
Aquí puedes comparar diversos objetos o juguetes usados como material de enriquecimiento ambiental para prevenir las mordeduras de cola en cerdos.
Un diccionario sobre terminología específica de la porcicultura
Un resumen semanal de las novedades de 3tres3 México
Diseño de instalaciones y equipos para granjas de cerdos: diseño de naves o casetas, climatización, sistemas de alimentación, etc. Comparadores de equipos.
Biocheck.UGent es un sistema de puntuación científico independiente, basado en riesgos, para evaluar la calidad de su bioseguridad en la granja.
Calculadora de la Huella Ambiental a lo largo de la cadena de valor del sector porcino
¿Qué comedero se adapta mejor a mis necesidades? Aquí puedes comparar las características de diversos comederos comerciales para cerdos.
¿Qué bebedero se adapta mejor a mis necesidades? Aquí puedes comparar las características de diversos bebederos comerciales para cerdos.
Un diccionario sobre terminología específica de la porcicultura
Utiliza esta herramienta para investigar qué estrategia de gestión de purines se adapta mejor a tu situación. Da click en el diagrama de flujo o en los botones dentro del texto para navegar por las distintas partes de la herramienta.
Un resumen semanal de las novedades de 3tres3 México
Aquí encontrarás los autores especialistas en porcicultura que colaboran en 3tres3.com con información de su currículum
Educación:
Graduado por la Universidad Estatal de Iowa en 1989.
Se doctoró en veterinaria (DVM) también de la Universidad Estatal de Iowa en 1993.
Obtuvo el Master en Salud Pública (MSP) de la Universidad de Iowa en 2004.
Certificado por el Colegio Americano de Medicina Preventiva Veterinaria en 2006 (Diplomado ACVPM).
Carrera hasta la fecha:
2021-Actualidad – Facultad de Medicina Veterinaria de la Universidad de Arizona - Decano Adjunto Senior, Programas Académicos y Asuntos Docentes. Deberes administrativos como líder y defensor de la innovación curricular, el desarrollo docente y el éxito. Supervisa la facultad y las prácticas de selección y contratación de profesores con el objetivo de brindar un equipo de educadores diverso, inclusivo, innovador y altamente calificado. Colabora de manera importante con los demás en el desarrollo e implementación de un proceso transparente, sólido y atractivo para ayudar a guiar y garantizar el éxito y el avance de la facultad. Supervisa el desarrollo y la implementación curricular basados en competencias, centrados en el alumno y avanzados, produciendo una experiencia educativa perfecta para todos los estudiantes. Promueve y apoya la integración de la investigación en el plan de estudios del DVM.
2020-Actualidad – Profesor en Diagnóstico Veterinario y Producción Animal y Decano Adjunto del Colegio de Medicina Veterinaria. Este cargo incluye enseñanza, investigación, práctica profesional, divulgación y administración académico y de servicios estudiantiles . Está involucrado en la enseñanza del currículum profesional de veterinario así como en programas de pregrado y postgrado. La investigación se centra en aplicación de herramientas de diagnóstico y enfermedades transmisibles incluyendo PRRS, Mycoplasma hyopneumoniae, Clostridium spp, MRSA, bioseguridad y enfermedades infecciosas de importancia para la salud pública.
2007-2020 – Profesor Adjunto en Diagnóstico Veterinario y Producción Animal. Este cargo incluye enseñanza, investigación, práctica profesional y divulgación. Está involucrado en la enseñanza del currículum profesional de veterinario así como en programas de pregrado y postgrado. La investigación se centra en enfermedades transmisibles incluyendo PRRS y Mycoplasma hyopneumoniae, Clostridium spp, MRSA, bioseguridad y enfermedades infecciosas de importancia para la salud pública.
2004-2007 – Especialista veterinario en la Universidad Estatal de Iowa. Trabajó tanto en el Centro de Seguridad Alimentaria y Salud Pública y el Departamento de Medicina de Producción Animal y Diagnóstico Veterinario. Se centró en la enseñanza, la práctica profesional y la divulgación. Trabajó especialmente en la veterinaria de la producción porcina, transmisión de enfermedades infecciosas, bioseguridad y enfermedades infecciosas de importancia en la salud pública.
1993-2004 – Trabajó en la empresa privada Valley Veterinary Center, con seis veterinarios multiespecie en Cherokee, Iowa. Su trabajo incluía la práctica ambulatoria en grandes animales, así como servicios de gestión para granjas de cerdos. Los clientes procedían en un 50% del porcino, 30% ganado (engorde de terneros y vacas), 15% de pequeños animales y un 5% de equinos & otros. En los últimos años estuvo básicamente involucrado en la gestión de la producción porcina para sus clientes y en la gestión de la clínica. Llevaba las bases de datos de registros de la clínica (PigCHAMP® y CowCalf5®) y su personal. También gestionaba la contabilidad de la clínica. Por lo que respecta a la gestión para sus clientes, era gerente de varias explotaciones haciendo visitas rutinarias.
Afiliciaciones Profesionales:
American Veterinary Medical Association (AVMA)
American Association of Bovine Practitioners (AABP)
American Association of Swine Veterinarians (AASV)
Judge for the Student Seminar Presentations (2006 – 2007)
Co-Chair for Student Seminar Presentations (2007)
Chair for Student Seminar Presentations (2008 – Actualidad)
Member of Collegiate Activities Committee (2007 – Actualidad)
Member of Foreign Animal Disease Committee (2008 – Actualidad)
Iowa Veterinary Medical Association (IVMA)
American College of Veterinary Preventive Medicine (ACVPM)
Ad Hoc Committee on ACVPM Board Preparation (2007 – 2008)
Iowa Pork Producers Association (IPPA)
Swine Health/Animal Well Being Committee (2007 – Actualidad)
National Pork Board (NPB)
Producer Safety and Public Health Subcommittee (2007 – Actualidad)
Grant Reviewer for Swine Health proposal (2007 – Actualidad)
Grant Reviewer for Public Health proposals (2008 – Actualidad)
Curriculum actualizado: 16-nov-2021

¿Qué métodos de diagnóstico laboratorial puedo usar para diagnosticar fiebre aftosa? ¿Cuál debo elegir según la situación? ¿Cómo interpreto los resultados?

¿Qué métodos de diagnóstico laboratorial puedo usar para diagnosticar APP en cerdos? ¿Cuál debo elegir según la situación? ¿Cómo interpreto los resultados?

¿Qué métodos de diagnóstico laboratorial puedo usar para diagnosticar la diarrea epidémica porcina? ¿Cuál debo elegir según la situación? ¿Cómo interpreto los resultados?

¿Qué métodos de diagnóstico laboratorial puedo usar para diagnosticar rotavirus? ¿Cuál debo elegir según la situación? ¿Cómo interpreto los resultados?
¿Qué métodos de diagnóstico laboratorial puedo usar para diagnosticar la disentería porcina? ¿Cuál debo elegir según la situación? ¿Cómo interpreto los resultados?

¿Qué métodos de diagnóstico laboratorial puedo usar para diagnosticar influenza A? ¿Cuál debo elegir según la situación? ¿Cómo interpreto los resultados?

¿Qué métodos de diagnóstico laboratorial puedo usar para diagnosticar rinitis atrófica? ¿Cuál debo elegir según la situación? ¿Cómo interpreto los resultados?

¿Qué métodos de diagnóstico laboratorial puedo usar para diagnosticar Parvovirus? ¿Cuál debo elegir según la situación? ¿Cómo interpreto los resultados?

Cosas a tener en cuenta cuando interpretamos los resultados positivos o negativos de un test ELISA.

En este artículo te explicamos cómo funcionan los test ELISA, qué detectan y cómo interpretar los resultados.

Cómo interpretar un resultado PCR negativo o positivo, con ejemplos concretos de lo que podría estar pasando.

Te explicamos cómo funciona la PCR y qué debemos tener en cuenta al interpretar los resultados.

¿Qué métodos de diagnóstico laboratorial puedo usar para diagnosticar salmonelosis? ¿Cuál debo elegir según la situación? ¿Cómo interpreto los resultados?

¿Qué métodos de diagnóstico laboratorial puedo usar para diagnosticar peste porcina clásica? ¿Cuál debo elegir según la situación? ¿Cómo interpreto los resultados?

¿Qué métodos de diagnóstico laboratorial puedo usar para diagnosticar la enfermedad de Glässer? ¿Cuál debo elegir según la situación? ¿Cómo interpreto los resultados?

¿Qué métodos de diagnóstico laboratorial puedo usar para diagnosticar M. hyo? ¿Cuál debo elegir según la situación? ¿Cómo interpreto los resultados?
Un resumen semanal de las novedades de 3tres3 México
Accede y apúntate a la lista
Bienvenido a 3tres3
Conecta, comparte y relaciónate con la mayor comunidad de profesionales del sector porcino.
¡Ya somos 209744 Usuarios!
Regístrate¿Ya eres miembro?Los usuarios pueden iniciar sesión con Google para personalizar su experiencia, guardar preferencias o acceder a funcionalidades adicionales




